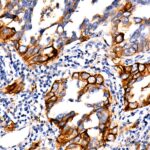

PD-L1/CD274 Rabbit mAb (A19135)
$148.00 – $548.00
Abclonal PD-L1/CD274 Rabbit mAb (Catalog Number: A19135) encodes an immune inhibitory receptor ligand that is expressed by hematopoietic and non-hematopoietic cells, such as T cells and B cells and various types of tumor cells.
- Details & Specifications
- References
| Catalog No. | A19135 |
|---|---|
| Product Name | PD-L1/CD274 Rabbit mAb (A19135) |
| Supplier Name | ABclonal, Inc. |
| Brand Name | Abclonal |
| Synonyms | B7-H; B7H1; PDL1; PD-L1; hPD-L1; PDCD1L1; PDCD1LG1 |
| Gene Name | CD274 |
| Protein Name | CD274 |
| Uniprot/Swissprot ID | Q9NZQ7 |
| Gene ID | 29126 |
| Clone | ARC2478 |
| Clonality | Monoclonal |
| Source/Host | Rabbit |
| Reactivity | Human |
| Conjugate | Unconjugated |
| Note | Products will be shipped from the warehouse in Massachusetts. Promotion is running from time to time. Welcome to send a request for quote to message@sydlabs.com. |
| Order Offline | Syd Labs, Inc. 4 Avenue E, Hopkinton, MA 01748 USA. Phone: 1-617-401-8149 Fax: 1-617-606-5019 Email: message@sydlabs.com |
Description
A19135: PD-L1/CD274 Rabbit mAb
This gene encodes an immune inhibitory receptor ligand that is expressed by hematopoietic and non-hematopoietic cells, such as T cells and B cells and various types of tumor cells. The encoded protein is a type I transmembrane protein that has immunoglobulin V-like and C-like domains. Interaction of this ligand with its receptor inhibits T-cell activation and cytokine production. During infection or inflammation of normal tissue, this interaction is important for preventing autoimmunity by maintaining homeostasis of the immune response. In tumor microenvironments, this interaction provides an immune escape for tumor cells through cytotoxic T-cell inactivation. Expression of this gene in tumor cells is considered to be prognostic in many types of human malignancies, including colon cancer and renal cell carcinoma. Alternative splicing results in multiple transcript variants.
Immunogen Information about PD-L1/CD274 Rabbit mAb (A19135)
Immunogen:Recombinant fusion protein containing a sequence corresponding to amino acids 1-290 of human PD-L1/CD274 (Q9NZQ7).
Sequence:MRIFAVFIFMTYWHLLNAFTVTVPKDLYVVEYGSNMTIECKFPVEKQLDLAALIVYWEMEDKNIIQFVHGEEDLKVQHSSYRQRARLLKDQLSLGNAALQITDVKLQDAGVYRCMISYGGADYKRITVKVNAPYNKINQRILVVDPVTSEHELTCQAEGYPKAEVIWTSSDHQVLSGKTTTTNSKREEKLFNVTSTLRINTTTNEIFYCTFRRLDPEENHTAELVIPELPLAHPPNERTHLVILGAILLCLGVALTFIFRLRKGRMMDVKKCGIQDTNSKKQSDTHLEET
Gene ID:29126
Swiss prot:Q9NZQ7
Synonyms:B7-H; B7H1; PDL1; PD-L1; hPD-L1; PDCD1L1; PDCD1LG1; PD-L1/CD274
Calculated MW:33kDa
Observed MW:40-50kDa
Images of PD-L1/CD274 Rabbit mAb (A19135)

Western blot analysis of lysates from wild type (WT) and PD-L1/CD274 knockout (KO) A549 cells using PD-L1/CD274 Rabbit mAb (A19135) at 1:1000 dilution.wild type (WT) and PD-L1/CD274 knockout (KO) A549 cells were treated by IFNG (100 ng/mL) at 37℃ for 48 hours.
Secondary antibody: HRP Goat Anti-Rabbit IgG (H+L) (AS014) at 1:10000 dilution.
Lysates/proteins: 25ug per lane.
Blocking buffer: 3% nonfat dry milk in TBST.
Detection: ECL Basic Kit (RM00020).
Exposure time: 60s.

Immunohistochemistry analysis of paraffin-embedded Human lung adenocarcinoma using PD-L1/CD274 Rabbit mAb (A19135) at dilution of 1:500 (40x lens).Perform high pressure antigen retrieval with 10 mM citrate buffer pH 6.0 before commencing with IHC staining protocol.

Immunohistochemistry analysis of paraffin-embedded human placenta using PD-L1/CD274 Rabbit mAb (A19135) at dilution of 1:500 (40x lens).Perform high pressure antigen retrieval with 10 mM citrate buffer pH 6.0 before commencing with IHC staining protocol.

Immunohistochemistry analysis of paraffin-embedded human tonsil using PD-L1/CD274 Rabbit mAb (A19135) at dilution of 1:500 (40x lens).Perform high pressure antigen retrieval with 10 mM citrate buffer pH 6.0 before commencing with IHC staining protocol.
Please remember our product information: PD-L1/CD274 Rabbit mAb (Catalog Number: A19135) Abclonal